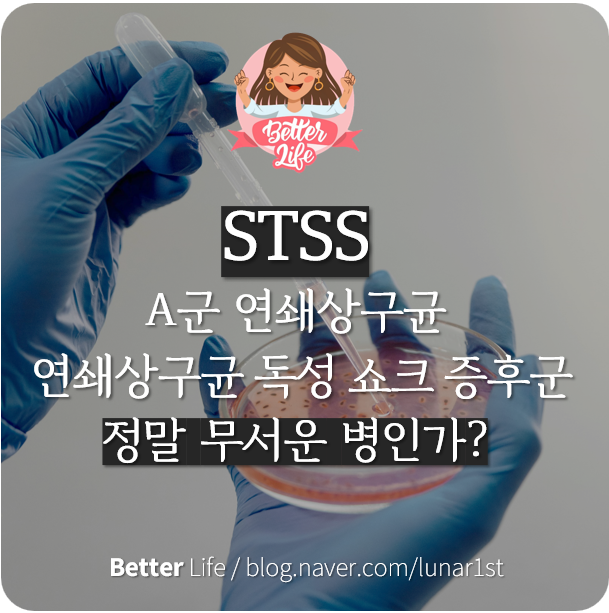

장폐색 증상 장이 꼬이는 느낌이 든다면 의심해 봐야 하는 병, 원인과 좋은 음식
2025.06.20

안녕하세요. 유방암과 건강/의학을 다루는 Better Life입니다. 장폐색은 장이 막히는 증상을 말하는데, ...
출처
https://blog.naver.com/lunar1st/223391375260
이슈모어 핫이슈
-
 김무열 참교육 공개 후 뜨거운 반응, 범죄도시4 빌런에서 정의 구현자로 완벽 변신
김무열 참교육이 공개 이후 시청자들 사이에서 입소문을 타며 관심을 모으고 있다. 넷플릭스 시리즈 ‘참교육’은…
김무열 참교육 공개 후 뜨거운 반응, 범죄도시4 빌런에서 정의 구현자로 완벽 변신
김무열 참교육이 공개 이후 시청자들 사이에서 입소문을 타며 관심을 모으고 있다. 넷플릭스 시리즈 ‘참교육’은…
-
 이승기 콘서트 13년 기다림 끝난다, 기승전 락으로 다시 증명할 가수의 시간
이승기 콘서트 소식이 공개되며 오랜 시간 그의 음악 무대를 기다려온 팬들의 관심이 집중되고 있다. 가수 겸 …
이승기 콘서트 13년 기다림 끝난다, 기승전 락으로 다시 증명할 가수의 시간
이승기 콘서트 소식이 공개되며 오랜 시간 그의 음악 무대를 기다려온 팬들의 관심이 집중되고 있다. 가수 겸 …
-
 BTS 완전체 향한 전 세계 기대감, 다시 모인 일곱 멤버가 열 다음 챕터
BTS 완전체를 향한 전 세계 팬들의 기대감이 다시 높아지고 있다. 방탄소년단은 데뷔 이후 K팝의 글로벌 확…
BTS 완전체 향한 전 세계 기대감, 다시 모인 일곱 멤버가 열 다음 챕터
BTS 완전체를 향한 전 세계 팬들의 기대감이 다시 높아지고 있다. 방탄소년단은 데뷔 이후 K팝의 글로벌 확…
관련 포스팅
Copyright blog.dowoo.me All right reserved.